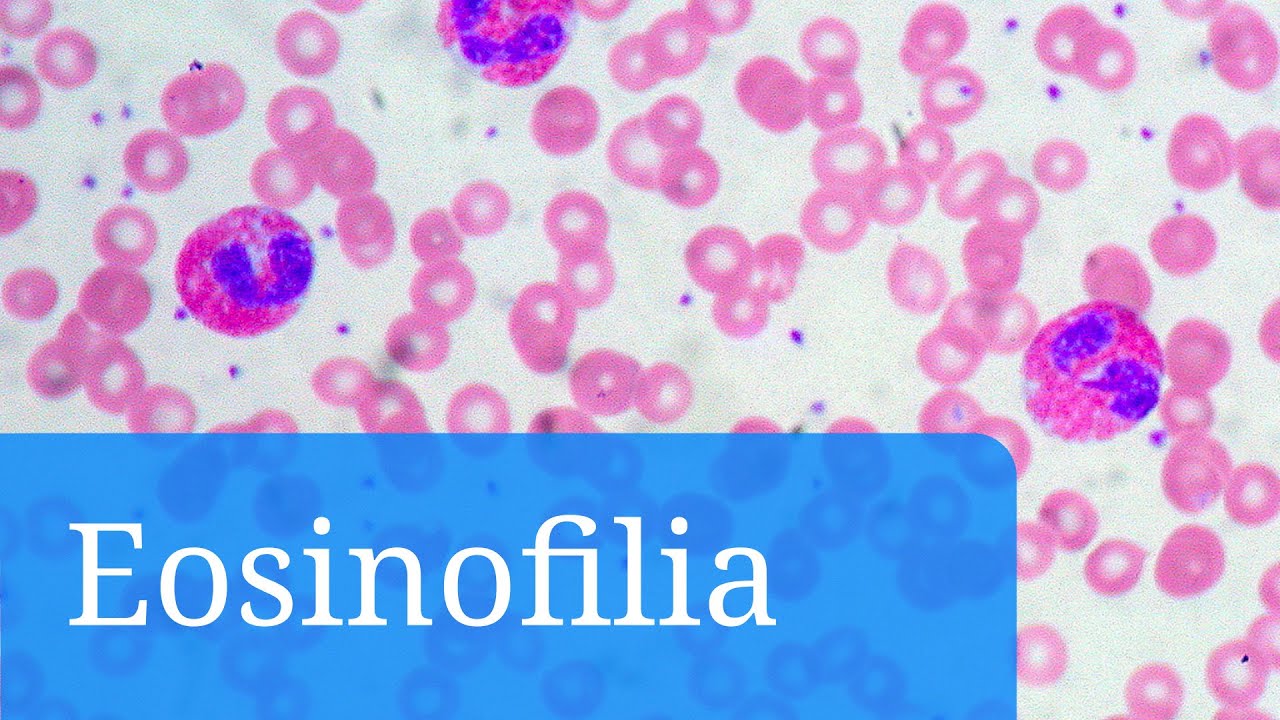
Eosinofilia: qu&eacute; indican los eosin&oacute;filos altos y cu&aacute;l es el tratamiento

Последние добавленные видео:
eosinofilos
-
 5 л. назад
33360 5 л. назад 6:41
5 л. назад
33360 5 л. назад 6:41Eosinófilo
-
 2 г. назад
22844 2 г. назад 1:01
2 г. назад
22844 2 г. назад 1:01Eosinofilos altos #nutricion
-
 8 л. назад
139553 8 л. назад 4:44
8 л. назад
139553 8 л. назад 4:44EOSINOFILOS ALTOS » Causas y Enfermedades de la Eosinofilia
-
10 л. назад
111751 10 л. назад 2:28
10 л. назад
111751 10 л. назад 2:28Eosinofilia: qué indican los eosinófilos altos y cuál es el tratamiento
-
 5 л. назад
52080 5 л. назад 3:58
5 л. назад
52080 5 л. назад 3:58Eosinofilos - 2 dicas para não assustar
-
 3 г. назад
86496 3 г. назад 5:41
3 г. назад
86496 3 г. назад 5:41Eozynofilowe zapalenie przełyku (NORD)
-
![EOSINÓFILOS [eosinofilia] altos no HEMOGRAMA, o que significa? | Geydson Cruz [MD,Msc]](https://imager.clipsaver.ru/eRHV3CDY994/max.jpg) 2 г. назад
25498 2 г. назад 19:43
2 г. назад
25498 2 г. назад 19:43EOSINÓFILOS [eosinofilia] altos no HEMOGRAMA, o que significa? | Geydson Cruz [MD,Msc]
-
 5 л. назад
10549 5 л. назад 2:32
5 л. назад
10549 5 л. назад 2:32Eosinófilos e Basófilos Altos
-
 3 г. назад
10717 3 г. назад 2:59
3 г. назад
10717 3 г. назад 2:59Glóbulos Brancos - monócitos, linfócitos, neutrófilos, eosinófilos, e basófilos.
-
 9 мес. назад
1790 9 мес. назад 1:19
9 мес. назад
1790 9 мес. назад 1:19Eosinófilos
-
 1 г. назад
2330 1 г. назад 4:06
1 г. назад
2330 1 г. назад 4:06Eosinofilia - sua dúvida respondida
-
 4 г. назад
30608 4 г. назад 4:08
4 г. назад
30608 4 г. назад 4:08Czynniki wyzwalające eozynofilowe zapalenie przełyku (EOE)
-
 Трансляция закончилась 2 г. назад
11708 Трансляция закончилась 2 г. назад 15:14
Трансляция закончилась 2 г. назад
11708 Трансляция закончилась 2 г. назад 15:14Eosinofilos
-
 10 л. назад
164213 10 л. назад 3:56
10 л. назад
164213 10 л. назад 3:56Eosinófilos. Cuál es su función y qué significa un nivel alto o bajo
-
 4 г. назад
5012 4 г. назад 2:04
4 г. назад
5012 4 г. назад 2:04EOSINÓFILOS VOCÊ SABE O QUE É